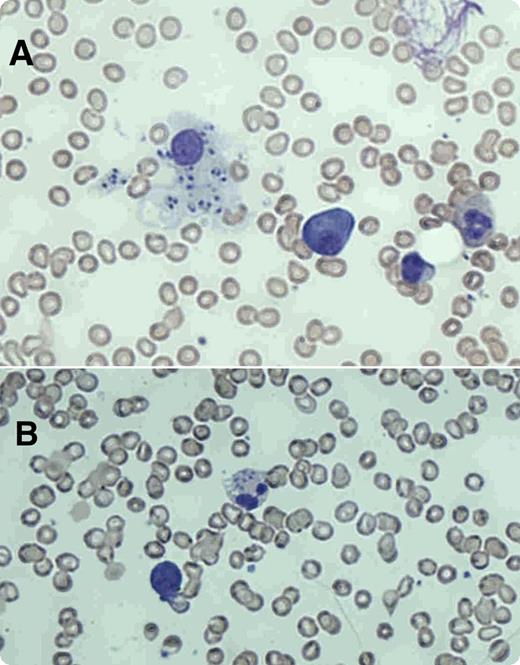
A 67-year-old white British man presented with a 2-month history of headache, fever, night sweats, and weight loss. Physical examination revealed splenomegaly. Laboratory tests showed a hemoglobin level of 111 g/L, white cell count of 1.5 × 109/L, neutrophil count of 0.4 × 109/L, and platelet count of 129 × 109/L. The man was HIV negative, and a blood film was nondiagnostic. Bone marrow aspirate showed (panel A) macrophages with intracellular forms of Leishmania amastigotes and (panel B) amastigote forms within a neutrophil. A culture of bone marrow in modified Novy-MacNeal-Nicolle media grew Leishmania promastigotes. Polymerase chain reaction with primers to amplify kinetoplast DNA minicircles on bone marrow was positive for Leishmania donovani. When asked retrospectively, he noted that he had delivered yachts in the Mediterranean over the last 5 years. His last trip to Portugal was 6 months before presentation. He had never traveled to the Indian subcontinent or central or east Africa where visceral leishmaniasis is endemic. The patient was treated with liposomal amphotericin B at a dose of 3 mg/kg/day from days 1 to 5 and day 10. His blood counts normalized, and his symptoms improved with regression of splenomegaly. / Visceral leishmaniasis has infrequently been reported from southern Europe, northern Africa, and the Mediterranean according to the World Health Organization and should be considered in travelers regardless of ethnicity.

A 67-year-old white British man presented with a 2-month history of headache, fever, night sweats, and weight loss. Physical examination revealed splenomegaly. Laboratory tests showed a hemoglobin level of 111 g/L, white cell count of 1.5 × 109/L, neutrophil count of 0.4 × 109/L, and platelet count of 129 × 109/L. The man was HIV negative, and a blood film was nondiagnostic. Bone marrow aspirate showed (panel A) macrophages with intracellular forms of Leishmania amastigotes and (panel B) amastigote forms within a neutrophil. A culture of bone marrow in modified Novy-MacNeal-Nicolle media grew Leishmania promastigotes. Polymerase chain reaction with primers to amplify kinetoplast DNA minicircles on bone marrow was positive for Leishmania donovani. When asked retrospectively, he noted that he had delivered yachts in the Mediterranean over the last 5 years. His last trip to Portugal was 6 months before presentation. He had never traveled to the Indian subcontinent or central or east Africa where visceral leishmaniasis is endemic. The patient was treated with liposomal amphotericin B at a dose of 3 mg/kg/day from days 1 to 5 and day 10. His blood counts normalized, and his symptoms improved with regression of splenomegaly.
Visceral leishmaniasis has infrequently been reported from southern Europe, northern Africa, and the Mediterranean according to the World Health Organization and should be considered in travelers regardless of ethnicity.
A 67-year-old white British man presented with a 2-month history of headache, fever, night sweats, and weight loss. Physical examination revealed splenomegaly. Laboratory tests showed a hemoglobin level of 111 g/L, white cell count of 1.5 × 109/L, neutrophil count of 0.4 × 109/L, and platelet count of 129 × 109/L. The man was HIV negative, and a blood film was nondiagnostic. Bone marrow aspirate showed (panel A) macrophages with intracellular forms of Leishmania amastigotes and (panel B) amastigote forms within a neutrophil. A culture of bone marrow in modified Novy-MacNeal-Nicolle media grew Leishmania promastigotes. Polymerase chain reaction with primers to amplify kinetoplast DNA minicircles on bone marrow was positive for Leishmania donovani. When asked retrospectively, he noted that he had delivered yachts in the Mediterranean over the last 5 years. His last trip to Portugal was 6 months before presentation. He had never traveled to the Indian subcontinent or central or east Africa where visceral leishmaniasis is endemic. The patient was treated with liposomal amphotericin B at a dose of 3 mg/kg/day from days 1 to 5 and day 10. His blood counts normalized, and his symptoms improved with regression of splenomegaly.
Visceral leishmaniasis has infrequently been reported from southern Europe, northern Africa, and the Mediterranean according to the World Health Organization and should be considered in travelers regardless of ethnicity.
For additional images, visit the ASH IMAGE BANK, a reference and teaching tool that is continually updated with new atlas and case study images. For more information visit http://imagebank.hematology.org.

This feature is available to Subscribers Only
Sign In or Create an Account Close Modal